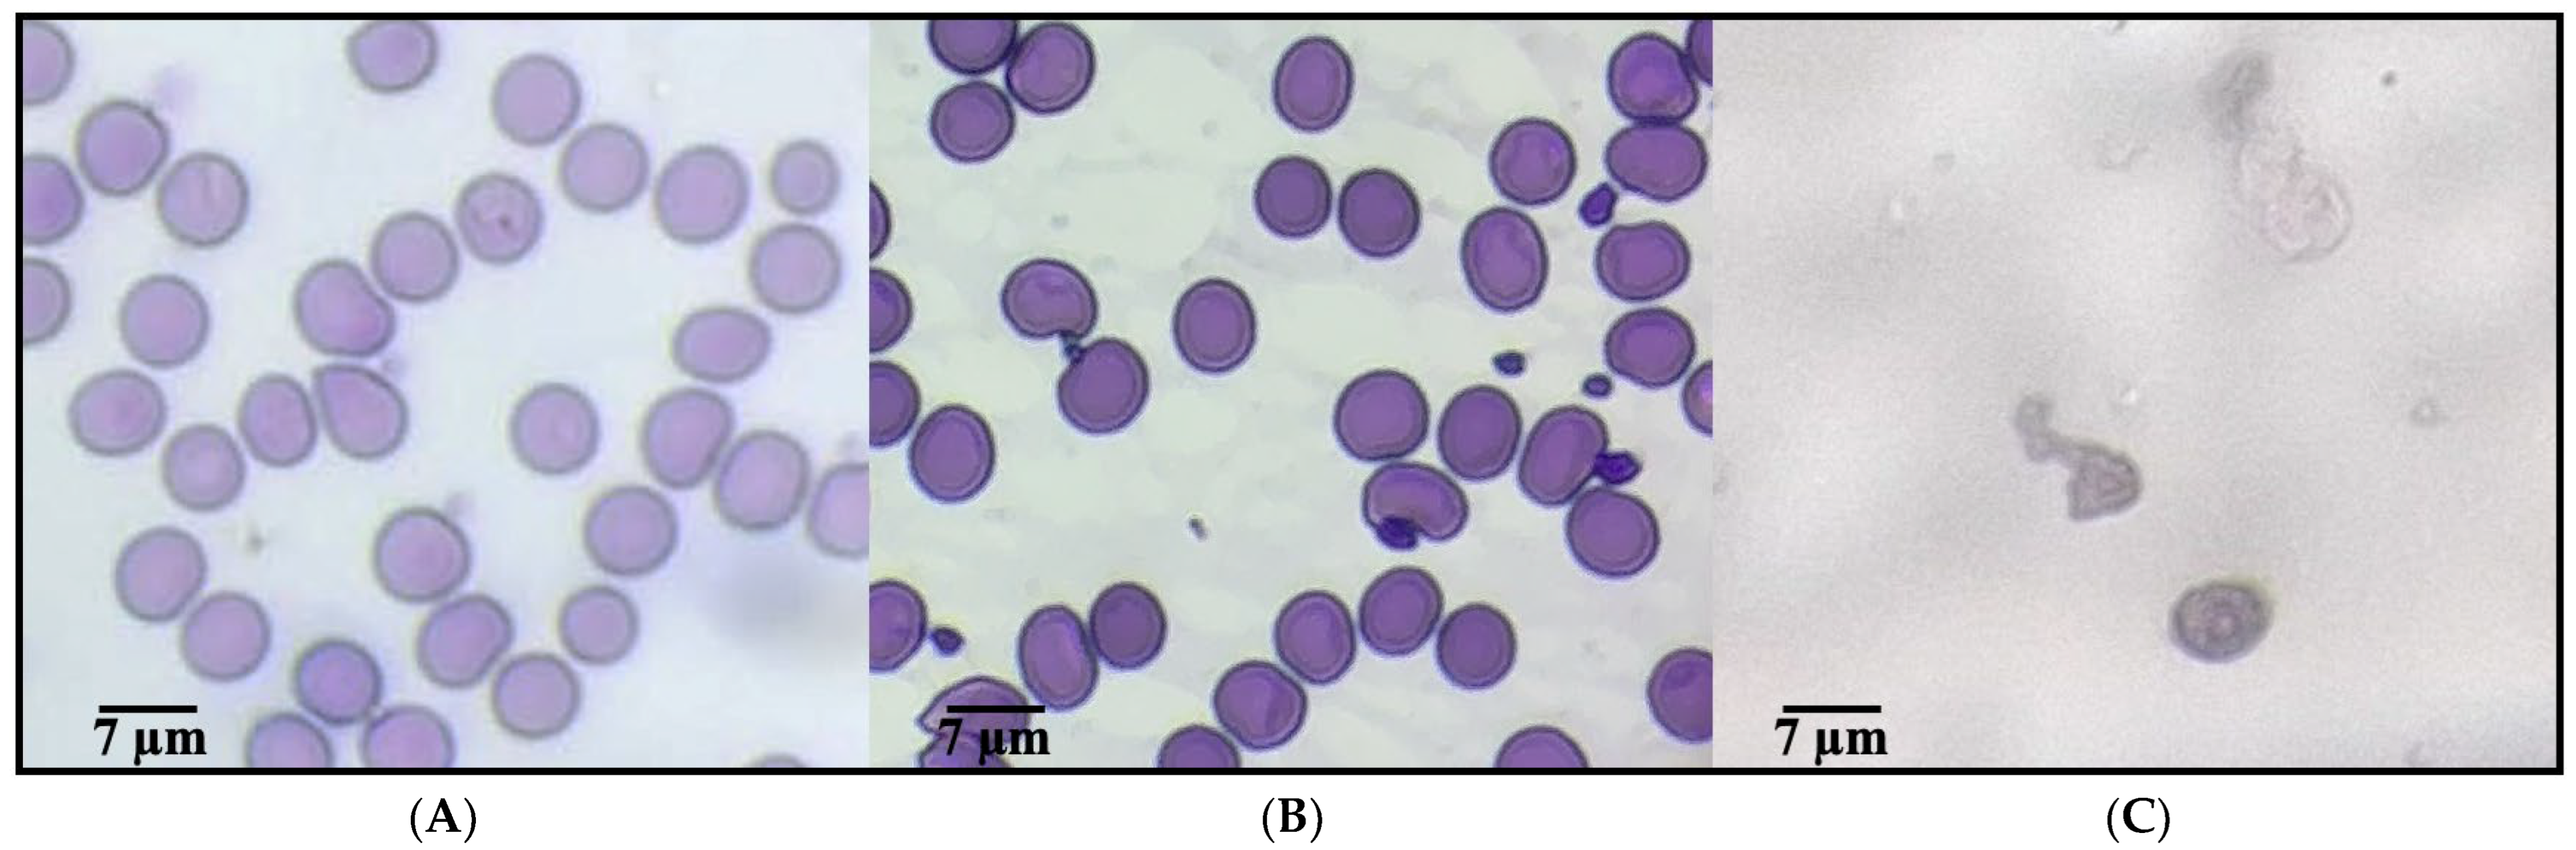
Ijms 26 09637 g001 Ijms 26 09637 g001

Assessment of a Functional Yogurt Enriched with Anthocyanin-Loaded Nanoliposomes: Sensory Evaluation and Physicochemical Stability During Cold Storage
Abstract
1. Introduction
2. Results and Discussion
2.1. Biological Activity
2.1.1. Antioxidant Activity
2.1.2. Erythroprotector Potential
2.1.3. Morphological Alterations of Erythrocytes Under Oxidative Stress
2.2. Evaluation of Encapsulation Performance and Controlled Release Behavior of Anthocyanin-Loaded Nanoliposomes
2.2.1. Encapsulation Efficiency
2.2.2. Assessment of Particle Size and Zeta Potential Stability
2.2.3. Aqueous Dispersibility Assay
2.2.4. In Vitro Release
2.2.5. Controlled Release Kinetics Korsmeyer–Peppas
2.2.6. Stability of ANT-LN by Centrifugation
2.3. Morphological Characterization of Anthocyanin-Loaded Nanoliposomes in Enriched Yogurt
2.4. Proximate Composition of Yogurt Enriched with Anthocyanin-Loaded Nanoliposomes
2.5. Microbiological Assessment of Artisanal Yogurt
2.6. Effect of Cold Storage Conditions on the Physicochemical and Rheological Properties of Yogurt Enriched with ANT-LN
2.6.1. pH
2.6.2. Titratable Acidity
2.6.3. Syneresis Susceptibility
2.6.4. Water-Holding Capacity (WHC)
2.6.5. Viscosity
2.6.6. Texture (Firmness and Consistency)
2.6.7. Rheological Analysis
2.7. Sensory Analysis
3. Materials and Methods
3.1. Ethical Handling of Human Erythrocyte Membrane-Based Assays
3.2. Extraction of Anthocyanins by High-Energy Ultrasound
3.3. Antioxidant Properties of Food-Grade Anthocyanins
3.4. Erythroprotective Potential
3.4.1. Protective Effect Against AAPH-Induced Oxidative Hemolysis
3.4.2. Photoprotective Effect Against UV Radiation-Induced Oxidative Hemolysis
3.5. Synthesis and Physicochemical Characterization of Anthocyanin-Loaded Nanoliposomes
3.5.1. Synthesis of Anthocyanin-Loaded Nanoliposomes
3.5.2. Encapsulation Efficiency
3.5.3. Assessment of Particle Size and Zeta Potential Stability
3.5.4. Aqueous Dispersibility Assay
3.5.5. In Vitro Release
3.6. Development of Functional Yogurt Enriched with Anthocyanin-Loaded Nanoliposomes
3.6.1. Preparation and Formulation of Artisanal Yogurt
3.6.2. Morphological Evaluation of Lyophilized Yogurt Enriched with Nanoliposomes
3.7. Chemical Characterization
3.8. Microbiological Assessment of Yogurt
3.9. Stability of ANT-LN Enriched Yogurt Under Cold Storage: Physicochemical and Rheological Insights
3.9.1. Determination of Physicochemical Properties
3.9.2. Texture
3.9.3. Rheological Analysis
3.10. Sensory Analysis
3.11. Statistical Analysis
4. Conclusions
Author Contributions
Funding
Institutional Review Board Statement
Informed Consent Statement
Data Availability Statement
Acknowledgments
Conflicts of Interest
References
- Sun, Y.; Chi, J.; Ye, X.; Wang, S.; Liang, J.; Yue, P.; Xiao, H.; Gao, X. Nanoliposomes as delivery system for anthocyanins: Physicochemical characterization, cellular uptake, and antioxidant properties. LWT 2021, 139, 110554. [Google Scholar] [CrossRef]
- Mozafari, M.R. Nanoliposomes: Preparation and Analysis. In Methods in Molecular Biology; Humana Press: Totowa, NJ, USA, 2010; pp. 29–50. [Google Scholar]
- Mozafari, M.R. Bioactive entrapment and targeting using nanocarrier technologies: An introduction. In Nanocarrier Technologies; Springer: Dordrecht, The Netherlands, 2006; pp. 1–16. [Google Scholar]
- Bhosale, S.; Fulpagare, Y.; Desale, R. Nanoliposomes: Applications in food and dairy industry. Int. J. Adv. Res. Biol. Sci. 2019, 6, 79–84. [Google Scholar]
- Aguilar-Pérez, K.M.; Avilés-Castrillo, J.I.; Medina, D.I.; Parra-Saldivar, R.; Iqbal, H.M.N. Insight Into Nanoliposomes as Smart Nanocarriers for Greening the Twenty-First Century Biomedical Settings. Front. Bioeng. Biotechnol. 2020, 8, 579536. [Google Scholar] [CrossRef]
- Wu, Y.; Wang, K.; Liu, Q.; Liu, X.; Mou, B.; Lai, O.-M.; Tan, C.-P.; Cheong, L.-Z. Selective antibacterial activities and storage stability of curcumin-loaded nanoliposomes prepared from bovine milk phospholipid and cholesterol. Food Chem. 2022, 367, 130700. [Google Scholar] [CrossRef]
- Hasan, M.; Elkhoury, K.; Kahn, C.J.F.; Arab-Tehrany, E.; Linder, M. Preparation, characterization, and release kinetics of chitosan-coated nanoliposomes encapsulating curcumin in simulated environments. Molecules 2019, 24, 2023. [Google Scholar] [CrossRef]
- Hasan, M.; Latifi, S.; Kahn, C.J.F.; Tamayol, A.; Habibey, R.; Passeri, E.; Linder, M.; Arab-Tehrany, E. The positive role of curcumin-loaded salmon nanoliposomes on the culture of primary cortical neurons. Mar. Drugs 2018, 16, 218. [Google Scholar] [CrossRef]
- Raftani Amiri, Z.; Rezaei Erami, S.; Jafari, S.M.; Ahmadian, S. Physicochemical properties of yogurt enriched with nanoliposomes containing bitter melon extract. LWT 2024, 198, 116091. [Google Scholar] [CrossRef]
- Asaduzzaman, M.; Mahomud, M.S.; Haque, M.E. Heat-Induced Interaction of Milk Proteins: Impact on Yoghurt Structure. Int. J. Food Sci. 2021, 2021, 5569917. [Google Scholar] [CrossRef] [PubMed]
- Tavakoli, H.; Hosseini, O.; Jafari, S.M.; Katouzian, I. Evaluation of physicochemical and antioxidant properties of yogurt enriched by olive leaf phenolics within nanoliposomes. J. Agric. Food Chem. 2018, 66, 9231–9240. [Google Scholar] [CrossRef]
- Rashwan, A.K.; Osman, A.I.; Chen, W. Natural nutraceuticals for enhancing yogurt properties: A review. Environ. Chem. Lett. 2023, 21, 1907–1931. [Google Scholar] [CrossRef]
- González-Vega, R.I.; Robles-García, M.Á.; Mendoza-Urizabel, L.Y.; Cárdenas-Enríquez, K.N.; Ruiz-Cruz, S.; Gutiérrez-Lomelí, M.; Iturralde-García, R.D.; Avila-Novoa, M.G.; Villalpando-Vargas, F.V.; Del-Toro-Sánchez, C.L. Impact of the ABO and RhD blood groups on the evaluation of the erythroprotective potential of fucoxanthin, β-Carotene, gallic acid, quercetin and ascorbic acid as therapeutic agents against oxidative stress. Antioxidants 2023, 12, 2092. [Google Scholar] [CrossRef]
- Anuyahong, T.; Chusak, C.; Adisakwattana, S. Incorporation of anthocyanin-rich riceberry rice in yogurts: Effect on physicochemical properties, antioxidant activity and in vitro gastrointestinal digestion. LWT 2020, 129, 109571. [Google Scholar] [CrossRef]
- Ghorbanzade, T.; Jafari, S.M.; Akhavan, S.; Hadavi, R. Nano-encapsulation of fish oil in nano-liposomes and its application in fortification of yogurt. Food Chem. 2017, 216, 146–152. [Google Scholar] [CrossRef]
- Azevedo, T.; Ferreira, T.; Ferreira, J.; Teixeira, F.; Ferreira, D.; Silva-Reis, R.; Neuparth, M.J.; Pires, M.J.; Pinto, M.d.L.; Gil da Costa, R.M.; et al. Supplementation of an anthocyanin-rich elderberry (Sambucus nigra L.) extract in fvb/n mice: A healthier alternative to synthetic colorants. Appl. Sci. 2022, 12, 11928. [Google Scholar] [CrossRef]
- Popova, N.V.; Vasiliev, A.K.; Kameneva, K.S. Antioxidant profile of plant-based probiotic beverages and its stability during digestion. BIO Web Conf. 2025, 179, 02004. [Google Scholar] [CrossRef]
- Zhang, L.; Wang, Y.; Cao, Y.; Wang, F.; Li, F. Enhancing the bioavailability and stability of anthocyanins for the prevention and treatment of central nervous system-related diseases. Foods 2025, 14, 2420. [Google Scholar] [CrossRef]
- Robles-García, M.Á.; Del-Toro-Sánchez, C.L.; Limón-Vargas, G.; Gutiérrez-Lomelí, M.; Avila-Novoa, M.G.; Villalpando-Vargas, F.V.; Vega-Ruiz, B.; Bernal-Mercado, A.T.; Iturralde-García, R.D.; Gómez-Guzman, A.I.P.; et al. Development of fucoxanthin-enriched yogurt using nanoliposomal carriers: A strategy for functional dairy products with antioxidant and erythroprotective benefits. Molecules 2025, 30, 1854. [Google Scholar] [CrossRef]
- Alkobeisi, F.; Varidi, M.J.; Varidi, M.; Nooshkam, M. Quinoa flour as a skim milk powder replacer in concentrated yogurts: Effect on their physicochemical, technological, and sensory properties. Food Sci. Nutr. 2022, 10, 1113–1125. [Google Scholar] [CrossRef] [PubMed]
- Almutairi, B.; Turner, M.S.; Fletcher, M.T.; Sultanbawa, Y. The impact of commercial prebiotics on the growth, survival and nisin production by Lactococcus lactis 537 in milk. LWT 2021, 137, 110356. [Google Scholar] [CrossRef]
- Wang, L.; Wang, L.; Wang, X.; Lu, B.; Zhang, J. Preparation of blueberry anthocyanin liposomes and changes of vesicle properties, physicochemical properties, in vitro release, and antioxidant activity before and after chitosan modification. Food Sci. Nutr. 2022, 10, 75–87. [Google Scholar] [CrossRef] [PubMed]
- Guldiken, B.; Gibis, M.; Boyacioglu, D.; Capanoglu, E.; Weiss, J. Physical and chemical stability of anthocyanin-rich black carrot extract-loaded liposomes during storage. Food Res. Int. 2018, 108, 491–497. [Google Scholar] [CrossRef]
- Sadowska-Bartosz, I.; Bartosz, G. Antioxidant activity of anthocyanins and anthocyanidins: A critical review. Int. J. Mol. Sci. 2024, 25, 12001. [Google Scholar] [CrossRef] [PubMed]
- Tena, N.; Martín, J.; Asuero, A.G. State of the art of anthocyanins: Antioxidant activity, sources, bioavailability, and therapeutic effect in human health. Antioxidants 2020, 9, 451. [Google Scholar] [CrossRef]
- Chaves, N.; Santiago, A.; Alías, J.C. Quantification of the antioxidant activity of plant extracts: Analysis of sensitivity and hierarchization based on the method used. Antioxidants 2020, 9, 76. [Google Scholar] [CrossRef]
- Sun, L.-L.; Gao, W.; Zhang, M.-M.; Li, C.; Wang, A.-G.; Su, Y.-L.; Ji, T.-F. Composition and antioxidant activity of the anthocyanins of the fruit of Berberis heteropoda Schrenk. Molecules 2014, 19, 19078–19096. [Google Scholar] [CrossRef] [PubMed]
- Wang, J.; Wang, J.; Hao, J.; Jiang, M.; Zhao, C.; Fan, Z. Antioxidant activity and structural characterization of anthocyanin–polysaccharide complexes from Aronia melanocarpa. Int. J. Mol. Sci. 2024, 25, 13347. [Google Scholar] [CrossRef] [PubMed]
- Medithi, S.; Jonnalagadda, P.R.; Jee, B. Predominant role of antioxidants in ameliorating the oxidative stress induced by pesticides. Arch. Environ. Occup. Health 2020, 76, 61–74. [Google Scholar] [CrossRef]
- He, R.-R.; Li, Y.; Li, X.-D.; Yi, R.-N.; Wang, X.-Y.; Tsoi, B.; Lee, K.K.H.; Abe, K.; Yang, X.; Kurihara, H. A new oxidative stress model, 2,2-azobis(2-amidinopropane) dihydrochloride induces cardiovascular damages in chicken embryo. PLoS ONE 2013, 8, e57732. [Google Scholar] [CrossRef]
- Morabito, R.; Romano, O.; La Spada, G.; Marino, A. H2O2-induced oxidative stress affects SO4 = transport in human erythrocytes. PLoS ONE 2016, 11, e0146485. [Google Scholar] [CrossRef]
- Coyle, C.H.; Martinez, L.J.; Coleman, M.C.; Spitz, D.R.; Weintraub, N.L.; Kader, K.N. Mechanisms of H2O2-induced oxidative stress in endothelial cells. Free Radic. Biol. Med. 2006, 40, 2206–2213. [Google Scholar] [CrossRef]
- Liu, R.H.; Finley, J. Potential Cell Culture Models for Antioxidant Research. J. Agric. Food Chem. 2005, 53, 4311–4314. [Google Scholar] [CrossRef] [PubMed]
- Simioni, C.; Schmidt, É.C.; Felix, M.R.d.L.; Polo, L.K.; Rover, T.; Kreusch, M.; Pereira, D.T.; Chow, F.; Ramlov, F.; Maraschin, M.; et al. Effects of ultraviolet radiation (UVA + UVB) on young gametophytes of Gelidium floridanum: Growth rate, photosynthetic pigments, carotenoids, photosynthetic performance, and ultrastructure. Photochem. Photobiol. 2014, 90, 1050–1060. [Google Scholar] [CrossRef]
- Parentini, I.; Bergamini, E.; Cecchi, L.; Cavallini, G.; Donati, A.; Maccheroni, M.; Tamburini, I.; Gorii, Z. The effect of carbon tetrachloride and ultraviolet radiation on dolichol levels in liver cells isolated from 3- and 24-month-old male Sprague-Dawley rats. Biogerontology 2003, 4, 365–370. [Google Scholar] [CrossRef]
- Sarıtaş, S.; Portocarrero, A.C.M.; Miranda López, J.M.; Lombardo, M.; Koch, W.; Raposo, A.; El-Seedi, H.R.; de Brito Alves, J.L.; Esatbeyoglu, T.; Karav, S.; et al. The impact of fermentation on the antioxidant activity of food products. Molecules 2024, 29, 3941. [Google Scholar] [CrossRef] [PubMed]
- Brand-Williams, W.; Cuvelier, M.E.; Berset, C. Use of a free radical method to evaluate antioxidant activity. LWT-Food Sci. Technol. 1995, 28, 25–30. [Google Scholar] [CrossRef]
- Re, R.; Pellegrini, N.; Proteggente, A.; Pannala, A.; Yang, M.; Rice-Evans, C. Antioxidant activity applying an improved ABTS radical cation decolorization assay. Free Radic. Biol. Med. 1999, 26, 1231–1237. [Google Scholar] [CrossRef]
- Benzie, I.F.F.; Strain, J.J. The Ferric Reducing Ability of Plasma (FRAP) as a Measure of “Antioxidant Power”: The FRAP Assay. Anal. Biochem. 1996, 239, 70–76. [Google Scholar] [CrossRef]
- Pan, L.; Wang, H.; Gu, K. Nanoliposomes as vehicles for astaxanthin: Characterization, in vitro release evaluation and structure. Molecules 2018, 23, 2822. [Google Scholar] [CrossRef]
- Taksima, T.; Limpawattana, M.; Klaypradit, W. Astaxanthin encapsulated in beads using ultrasonic atomizer and application in yogurt as evaluated by consumer sensory profile. LWT-Food Sci. Technol. 2015, 62, 431–437. [Google Scholar] [CrossRef]
- Rodriguez-Ruiz, V.; Salatti-Dorado, J.Á.; Barzegari, A.; Nicolas-Boluda, A.; Houaoui, A.; Caballo, C.; Caballero-Casero, N.; Sicilia, D.; Bastias Venegas, J.; Pauthe, E.; et al. Astaxanthin-loaded nanostructured lipid carriers for preservation of antioxidant activity. Molecules 2018, 23, 2601. [Google Scholar] [CrossRef] [PubMed]
- Jiao, Y.; Li, D.; Liu, C.; Chang, Y.; Song, J.; Xiao, Y. Polypeptide–decorated nanoliposomes as novel delivery systems for lutein. RSC Adv. 2018, 8, 31372–31381. [Google Scholar] [CrossRef]
- Chi, J.; Ge, J.; Yue, X.; Liang, J.; Sun, Y.; Gao, X.; Yue, P. Preparation of nanoliposomal carriers to improve the stability of anthocyanins. LWT 2019, 109, 101–107. [Google Scholar] [CrossRef]
- Yuan, C.; Jin, Z.; Xu, X. Inclusion complex of astaxanthin with hydroxypropyl-β-cyclodextrin: UV, FTIR, 1H NMR and molecular modeling studies. Carbohydr. Polym. 2012, 89, 492–496. [Google Scholar] [CrossRef] [PubMed]
- Al-Khayri, J.M.; Asghar, W.; Akhtar, A.; Ayub, H.; Aslam, I.; Khalid, N.; Al-Mssallem, M.Q.; Alessa, F.M.; Ghazzawy, H.S.; Attimarad, M. Anthocyanin Delivery Systems: A Critical Review of Recent Research Findings. Appl. Sci. 2022, 12, 12347. [Google Scholar] [CrossRef]
- Righi da Rosa, J.; Nunes, G.L.; Motta, M.H.; Fortes, J.P.; Cezimbra Weis, G.C.; Rychecki Hecktheuer, L.H.; Muller, E.I.; Ragagnin de Menezes, C.; Severo da Rosa, C. Microencapsulation of anthocyanin compounds extracted from blueberry (Vaccinium spp.) by spray drying: Characterization, stability and simulated gastrointestinal conditions. Food Hydrocoll. 2019, 89, 742–748. [Google Scholar] [CrossRef]
- Bierzuńska, P.; Cais-Sokolińska, D.; Yiğit, A. Storage stability of texture and sensory properties of yogurt with the addition of polymerized whey proteins. Foods 2019, 8, 548. [Google Scholar] [CrossRef]
- Rashwan, A.K.; Karim, N.; Xu, Y.; Xie, J.; Cui, H.; Mozafari, M.R.; Chen, W. Potential micro-/nano-encapsulation systems for improving stability and bioavailability of anthocyanins: An updated review. Crit. Rev. Food Sci. Nutr. 2021, 63, 3362–3385. [Google Scholar] [CrossRef]
- Jiao, Z.; Wang, X.; Yin, Y.; Xia, J.; Mei, Y. Preparation and evaluation of a chitosan-coated antioxidant liposome containing vitamin C and folic acid. J. Microencapsul. 2018, 35, 272–280. [Google Scholar] [CrossRef] [PubMed]
- Zhang, L.; Aniya; Xing, S.; Li, J.; Liu, Y.; Li, C.; Zhu, J.; Li, Y.; Fu, X. Preparation, physicochemical properties and stability of anthocyanin nanoliposomes before and after double-layer modification using synanthrin and pea protein isolate. Molecules 2025, 30, 2892. [Google Scholar] [CrossRef]
- Hudiyanti, D.; Putri, V.N.R.; Hikmahwati, Y.; Christa, S.M.; Siahaan, P.; Anugrah, D.S.B. Interaction of phospholipid, cholesterol, beta-carotene, and vitamin C molecules in liposome-based drug delivery systems: An in silico study. Adv. Pharmacol. Pharm. Sci. 2023, 2023, 4301310. [Google Scholar] [CrossRef]
- Tan, C.; Xue, J.; Lou, X.; Abbas, S.; Guan, Y.; Feng, B.; Zhang, X.; Xia, S. Liposomes as delivery systems for carotenoids: Comparative studies of loading ability, storage stability and in vitro release. Food Funct. 2014, 5, 1232. [Google Scholar] [CrossRef] [PubMed]
- Liao, H.; Yang, X.; Shi, X.; Wang, J.; Xia, T.; Yang, S.; He, Q.; Xiong, X.; Liu, L.; Sun, C. AIE-fluorescent TPENC12 nanoliposome: Construction and characterization of optical properties. J. Clust. Sci. 2024, 36, 14. [Google Scholar] [CrossRef]
- Tamjidi, F.; Shahedi, M.; Varshosaz, J.; Nasirpour, A. Design and characterization of astaxanthin-loaded nanostructured lipid carriers. Innov. Food Sci. Emerg. Technol. 2014, 26, 366–374. [Google Scholar] [CrossRef]
- Wang, Q.; Zhao, Y.; Guan, L.; Zhang, Y.; Dang, Q.; Dong, P.; Li, J.; Liang, X. Preparation of astaxanthin-loaded DNA/chitosan nanoparticles for improved cellular uptake and antioxidation capability. Food Chem. 2017, 227, 9–15. [Google Scholar] [CrossRef]
- Acurio Arcos, L.P.; Cadena Masabanda, W.A.; García Pazmiño, M.E.; Castillo Garzón, J.B.; Santiana Espín, C.G. Physicochemical, rheological, sensory, and proximal properties of yogurt flavored with Aloe vera gel. Emir. J. Food Agric. 2024, 36, 1–12. [Google Scholar] [CrossRef]
- NOM-243-SSA1-2010; Ministry of Health-Mexico Official Mexican Standard. Products and Services. Milk, Milk Formula, Combined Dairy Products and Dairy Derivatives. Sanitary Provisions and Specifications. Test Methods. Ministry of Health: Acapulco, Mexico. Available online: https://www.fao.org/faolex/results/details/en/c/LEX-FAOC097698/ (accessed on 10 April 2025).
- Sahin, O.I.; Dundar, A.N.; Ozdemir, S.; Uzuner, K.; Parlak, M.E.; Dagdelen, A.F.; Saricaoglu, F.T. Nanophytosomes as a protection system to improve the gastrointestinal stability and bioavailability of phycocyanin. Food Biosci. 2022, 50, 102052. [Google Scholar] [CrossRef]
- Peng, C.-H.; Chang, C.-H.; Peng, R.Y.; Chyau, C.-C. Improved membrane transport of astaxanthine by liposomal encapsulation. Eur. J. Pharm. Biopharm. 2010, 75, 154–161. [Google Scholar] [CrossRef]
- Peng, J.; Yuan, J.-P.; Wu, C.-F.; Wang, J.-H. Fucoxanthin, a marine carotenoid present in brown seaweeds and diatoms: Metabolism and bioactivities relevant to human health. Mar. Drugs 2011, 9, 1806–1828. [Google Scholar] [CrossRef] [PubMed]
- Mahfoudhi, N.; Ksouri, R.; Hamdi, S. Nanoemulsions as potential delivery systems for bioactive compounds in food systems: Preparation, characterization, and applications in food industry. In Emulsions; Elsevier: Amsterdam, The Netherlands, 2016; pp. 365–403. [Google Scholar]
- Mok, I.-K.; Lee, J.K.; Kim, J.H.; Pan, C.-H.; Kim, S.M. Fucoxanthin bioavailability from fucoxanthin-fortified milk: In vivo and in vitro study. Food Chem. 2018, 258, 79–86. [Google Scholar] [CrossRef] [PubMed]
- Gürbüz, Z.; Erkaya-Kotan, T.; Şengül, M. Evaluation of physicochemical, microbiological, texture and microstructure characteristics of set-style yoghurt supplemented with quince seed mucilage powder as a novel natural stabiliser. Int. Dairy J. 2021, 114, 104938. [Google Scholar] [CrossRef]
- Gyawali, R.; Ibrahim, S.A. Effects of hydrocolloids and processing conditions on acid whey production with reference to Greek yogurt. Trends Food Sci. Technol. 2016, 56, 61–76. [Google Scholar] [CrossRef]
- Mehra, R.; Kumar, H.; Rafiq, S.; Kumar, N.; Buttar, H.S.; Leicht, K.; Okpala, C.O.R.; Korzeniowska, M. Enhancing yogurt products’ ingredients: Preservation strategies, processing conditions, analytical detection methods, and therapeutic delivery—An overview. PeerJ 2022, 10, e14177. [Google Scholar] [CrossRef]
- Aportela-Palacios, A.; Sosa-Morales, M.E.; VÉLez-Ruiz, J.F. Rheological and physicochemical behavior of fortified yogurt, with fiber and calcium. J. Texture Stud. 2005, 36, 333–349. [Google Scholar] [CrossRef]
- Chen, Y.; He, N.; Yang, T.; Cai, S.; Zhang, Y.; Lin, J.; Huang, M.; Chen, W.; Zhang, Y.; Hong, Z. Fucoxanthin loaded in palm stearin- and cholesterol-based solid lipid nanoparticle-microcapsules, with improved stability and bioavailability in vivo. Mar. Drugs 2022, 20, 237. [Google Scholar] [CrossRef] [PubMed]
- Sridhar, K.; Inbaraj, B.S.; Chen, B.-H. Recent advances on nanoparticle based strategies for improving carotenoid stability and biological activity. Antioxidants 2021, 10, 713. [Google Scholar] [CrossRef]
- Pelaes Vital, A.C.; Goto, P.A.; Hanai, L.N.; Gomes-da-Costa, S.M.; de Abreu Filho, B.A.; Nakamura, C.V.; Matumoto-Pintro, P.T. Microbiological, functional and rheological properties of low fat yogurt supplemented with Pleurotus ostreatus aqueous extract. LWT-Food Sci. Technol. 2015, 64, 1028–1035. [Google Scholar] [CrossRef]
- Felix da Silva, D.; Junior, N.N.T.; Gomes, R.G.; dos Santos Pozza, M.S.; Britten, M.; Matumoto-Pintro, P.T. Physical, microbiological and rheological properties of probiotic yogurt supplemented with grape extract. J. Food Sci. Technol. 2017, 54, 1608–1615. [Google Scholar] [CrossRef]
- Gharibzahedi, S.M.T.; Chronakis, I.S. Crosslinking of milk proteins by microbial transglutaminase: Utilization in functional yogurt products. Food Chem. 2018, 245, 620–632. [Google Scholar] [CrossRef] [PubMed]
- Guggisberg, D.; Cuthbert-Steven, J.; Piccinali, P.; Bütikofer, U.; Eberhard, P. Rheological, microstructural and sensory characterization of low-fat and whole milk set yoghurt as influenced by inulin addition. Int. Dairy J. 2009, 19, 107–115. [Google Scholar] [CrossRef]
- Liu, D.; Lv, X.X. Effect of blueberry flower pulp on sensory, physicochemical properties, lactic acid bacteria, and antioxidant activity of set-type yogurt during refrigeration. J. Food Process. Preserv. 2018, 43, e13856. [Google Scholar] [CrossRef]
- de Campo, C.; Queiroz Assis, R.; Marques da Silva, M.; Haas Costa, T.M.; Paese, K.; Stanisçuaski Guterres, S.; de Oliveira Rios, A.; Hickmann Flôres, S. Incorporation of zeaxanthin nanoparticles in yogurt: Influence on physicochemical properties, carotenoid stability and sensory analysis. Food Chem. 2019, 301, 125230. [Google Scholar] [CrossRef]
- Najgebauer-Lejko, D.; Żmudziński, D.; Ptaszek, A.; Socha, R. Textural properties of yogurts with green tea and Pu-erh tea additive. Int. J. Food Sci. Technol. 2013, 49, 1149–1158. [Google Scholar] [CrossRef]
- Shokery, E.S.; El Ziney, M.G.; Yossef, A.H.; Mashaly, R.I. Effect of green tea and moringa leave extracts fortification on the physicochemical, rheological, sensory and antioxidant properties of set-type yoghurt. Adv. Dairy Res. 2017, 5, 2. [Google Scholar] [CrossRef]
- Athar, I.H.; Shah, M.A.; Khan, U. Effect of various stabilizers on whey separation (syneresis) and quality of yoghurt. Pak. J. Biol. Sci. 2000, 3, 1336–1338. [Google Scholar] [CrossRef]
- Blejan, A.M.; Nour, V.; Corbu, A.R.; Codină, G.G. Influence of bilberry pomace powder addition on the physicochemical, functional, rheological, and sensory properties of stirred yogurt. Gels 2024, 10, 616. [Google Scholar] [CrossRef]
- Borjizadeh, Z.; Ahari, H.; Özdal, T.; Khosravi-Darani, K.; Nafchi, A.M. Saffron nanoencapsulation (Crocus sativus) and its role in food science: Types and techniques. ACS Food Sci. Technol. 2024, 4, 1310–1333. [Google Scholar] [CrossRef]
- Radi, U.M.A.; Doosh, K.S. Study of the physiochemical and sensory properties of therapeutic low-cholesterol yoghurt fortified with zinc nanoparticles. IOP Conf. Ser. Earth Environ. Sci. 2023, 1262, 062029. [Google Scholar] [CrossRef]
- Schram, L.B.; Nielsen, C.J.; Porsgaard, T.; Nielsen, N.S.; Holm, R.; Mu, H. Food matrices affect the bioavailability of (n − 3) polyunsaturated fatty acids in a single meal study in humans. Food Res. Int. 2007, 40, 1062–1068. [Google Scholar] [CrossRef]
- Machado, K.; Tulini, F.; Guimarães, J.; Moraes, I.; Ditchfield, C.; Lima, C.; Silva, V.; Favaro-Trindade, C. Production and evaluation of yogurt colored with anthocyanin-rich pigment prepared from jabuticaba (Myrciaria cauliflora Mart.) skin. Processes 2023, 11, 526. [Google Scholar] [CrossRef]
- Matos, J.; Afonso, C.; Cardoso, C.; Serralheiro, M.L.; Bandarra, N.M. Yogurt enriched with Isochrysis galbana: An innovative functional food. Foods 2021, 10, 1458. [Google Scholar] [CrossRef]
- NOM-253-SSA1-2012; Ministry of Health-Mexico Official Mexican Standard. For the Disposal of Human Blood and Its Components for Therapeutic Purposes. Ministry of Health: Acapulco, Mexico. Available online: https://www.dof.gob.mx/nota_detalle.php?codigo=5272787&fecha=26/10/2012/ (accessed on 10 April 2025).
- ISO/IEC-17025; General Requirements for the Competence of Testing and Calibration Laboratories. ISO: Geneva, Switzerland. Available online: https://www.iso.org/obp/ui/#iso:std:iso-iec:17025:ed-3:v2:es (accessed on 28 October 2024).
- ISO-15189:2022; Medical Laboratories—Requirements for Quality and Competence. ISO: Geneva, Switzerland. Available online: https://www.iso.org/obp/ui/#iso:std:iso:15189:ed-4:v1:en (accessed on 28 October 2024).
- ISO/TC-212; Clinical Laboratory Testing and In Vitro Diagnostic Test Systems. ISO: Geneva, Switzerland. Available online: https://www.iso.org/committee/54916.html (accessed on 28 October 2024).
- ISO-9001:2015; Quality Management Systems. ISO: Geneva, Switzerland. Available online: https://www.iso.org/obp/ui/#iso:std:iso:9001:ed-5:v1:en (accessed on 28 October 2024).
- Peña-Medina, R.L.; Fimbres-Olivarría, D.; Enríquez-Ocaña, L.F.; Martínez-Córdova, L.R.; Del-Toro-Sánchez, C.L.; López-Elías, J.A.; González-Vega, R.I. Erythroprotective potential of phycobiliproteins extracted from Porphyridium cruentum. Metabolites 2023, 13, 366. [Google Scholar] [CrossRef]
- Ruiz-Cruz, S.; González-Vega, R.I.; Robles-Zepeda, R.E.; Reyes-Díaz, A.; López-Elías, J.A.; Álvarez-Ainza, M.L.; Cinco-Moroyoqui, F.J.; Moreno-Corral, R.A.; Wong-Corral, F.J.; Borboa-Flores, J.; et al. Association of different ABO and Rh blood groups with the erythroprotective effect of extracts from Navicula incerta and their anti-inflammatory and antiproliferative properties. Metabolites 2022, 12, 1203. [Google Scholar] [CrossRef] [PubMed]
- González-Vega, R.I.; Cárdenas-López, J.L.; López-Elías, J.A.; Ruiz-Cruz, S.; Reyes-Díaz, A.; Perez-Perez, L.M.; Cinco-Moroyoqui, F.J.; Robles-Zepeda, R.E.; Borboa-Flores, J.; Del-Toro-Sánchez, C.L. Optimization of growing conditions for pigments production from microalga Navicula incerta using response surface methodology and its antioxidant capacity. Saudi J. Biol. Sci. 2021, 28, 1401–1416. [Google Scholar] [CrossRef] [PubMed]
- AOAC. Official Methods of Analysis, 15th ed.; Association of Official Analytical Chemists: Arlington, VA, USA, 1990. [Google Scholar]
- FAO. The State of World Fisheries and Aquaculture 2022: Towards Blue Transformation; FAO: Rome, Italy, 2018. [Google Scholar]
- AOCS. Official Methods and Recommended Practices of the American Oil Chemists’ Society; AOCS Press: Champaign, IL, USA, 2007. [Google Scholar]
- AOAC. The Official Methods of Analysis, 17th ed.; Association of Official Analytical Chemists: Gaithersburg, MD, USA, 2000. [Google Scholar]
- Achanta, K.; Aryana, K.J.; Boeneke, C.A. Fat free plain set yogurts fortified with various minerals. LWT-Food Sci. Technol. 2007, 40, 424–429. [Google Scholar] [CrossRef]
- Lawless, H.T.; Heymann, H. Sensory evaluation of food. In Food Science Text Series; Springer: New York, NY, USA, 2010. [Google Scholar]
- Kristl, J.; Teskač, K.; Caddeo, C.; Abramović, Z.; Šentjurc, M. Improvements of cellular stress response on resveratrol in liposomes. Eur. J. Pharm. Biopharm. 2009, 73, 253–259. [Google Scholar] [CrossRef]
- Stone, H.; Sidel, J.L. Sensory Evaluation Practices, 2nd ed.; Academic Press, Inc.: San Diego, CA, USA, 1993; Volume 93, p. 1351. [Google Scholar]

| Formulation | EE (%) | Particle Size (nm) | Polydispersity Index (PDI) | Zeta Potential (mV) | Interpretation |
|---|---|---|---|---|---|
| ANT-LN | 91.34 ± 1.34 | 132 ± 14.23 | 0.21 ± 0.031 | −34.61 ± 1.82 | Small, homogeneous vesicles with high EE and strong electrostatic stability, optimal for functional applications. |
| Total Dry Weight | ||||||
|---|---|---|---|---|---|---|
| Samples | Dry Matter (%) | Moisture (%) | Protein (%) | Fat (%) | Carbohydrates (%) | Ashes (%) |
| Y-C | 11.6 ± 1.3 b | 88.4 ± 1.5 a | 35.1 ± 2.8 a | 32.4 ± 2.5 a | 26.0 ± 1.5 a | 6.5 ± 0.7 a |
| Y-ANT-5 | 15.8 ± 1.32 a | 84.2 ± 1.6 b | 37.2 ± 2.3 a | 33.8 ± 2.3 a | 21.9 ± 1.7 b | 7.1 ± 0.5 a |
| Y-ANT-10 | 12.2 ± 2.75 ab | 87.8 ± 1.3 ab | 34.4 ± 1.53 a | 33.6 ± 2.1 a | 25.2 ± 2.5 ab | 6.8 ± 0.8 a |
| Sensory Quality Attributes | Treatments | ![]() | ||
| Y-C | Y-Ant-5 | Y-Ant-10 | ||
| Color | 8.64 ± 0.16 a | 8.45 ± 0.26 a | 7.91 ± 0.62 a | |
| Flavor | 7.91 ± 0.23 a | 6.73 ± 0.42 b | 5.64 ± 0.34 c | |
| Aftertaste | 7.27 ± 0.26 b | 7.64 ± 0.25 a | 6.34 ± 0.73 a | |
| Scent | 8.64 ± 0.45 a | 8.36 ± 0.45 ab | 7.73 ± 0.23 b | |
| Consistency | 8.27 ± 0.35 a | 7.73 ± 0.34 ab | 7.55 ± 0.34 b | |
| Texture | 8.18 ± 0.23 a | 7.73 ± 0.65 a | 7.91 ± 0.45 a | |
| Appearance | 8.27 ± 0.32 a | 8.00 ± 0.32 a | 6.64 ± 0.34 b | |
| General acceptance | 7.91 ± 0.15 a | 7.85 ± 0.21 a | 7.45 ± 0.23 a | |
Disclaimer/Publisher’s Note: The statements, opinions and data contained in all publications are solely those of the individual author(s) and contributor(s) and not of MDPI and/or the editor(s). MDPI and/or the editor(s) disclaim responsibility for any injury to people or property resulting from any ideas, methods, instructions or products referred to in the content. |
© 2025 by the authors. Licensee MDPI, Basel, Switzerland. This article is an open access article distributed under the terms and conditions of the Creative Commons Attribution (CC BY) license (https://creativecommons.org/licenses/by/4.0/).
Share and Cite
Robles-García, M.Á.; Del-Toro-Sánchez, C.L.; Tapia-Beiza, L.J.; Gutiérrez-Lomelí, M.; Avila-Novoa, M.G.; Bernal-Mercado, A.T.; Reynoso-Marín, F.J.; Villalpando-Vargas, F.V.; Vázquez-Aguilar, A.; Ramírez-Briones, E.; et al. Assessment of a Functional Yogurt Enriched with Anthocyanin-Loaded Nanoliposomes: Sensory Evaluation and Physicochemical Stability During Cold Storage. Int. J. Mol. Sci. 2025, 26, 9637. https://doi.org/10.3390/ijms26199637
Robles-García MÁ, Del-Toro-Sánchez CL, Tapia-Beiza LJ, Gutiérrez-Lomelí M, Avila-Novoa MG, Bernal-Mercado AT, Reynoso-Marín FJ, Villalpando-Vargas FV, Vázquez-Aguilar A, Ramírez-Briones E, et al. Assessment of a Functional Yogurt Enriched with Anthocyanin-Loaded Nanoliposomes: Sensory Evaluation and Physicochemical Stability During Cold Storage. International Journal of Molecular Sciences. 2025; 26(19):9637. https://doi.org/10.3390/ijms26199637
Chicago/Turabian StyleRobles-García, Miguel Ángel, Carmen Lizette Del-Toro-Sánchez, Linthia Jovana Tapia-Beiza, Melesio Gutiérrez-Lomelí, María Guadalupe Avila-Novoa, Ariadna Thalía Bernal-Mercado, Francisco Javier Reynoso-Marín, Fridha Viridiana Villalpando-Vargas, Alejandra Vázquez-Aguilar, Ernesto Ramírez-Briones, and et al. 2025. "Assessment of a Functional Yogurt Enriched with Anthocyanin-Loaded Nanoliposomes: Sensory Evaluation and Physicochemical Stability During Cold Storage" International Journal of Molecular Sciences 26, no. 19: 9637. https://doi.org/10.3390/ijms26199637
APA StyleRobles-García, M. Á., Del-Toro-Sánchez, C. L., Tapia-Beiza, L. J., Gutiérrez-Lomelí, M., Avila-Novoa, M. G., Bernal-Mercado, A. T., Reynoso-Marín, F. J., Villalpando-Vargas, F. V., Vázquez-Aguilar, A., Ramírez-Briones, E., & González-Vega, R. I. (2025). Assessment of a Functional Yogurt Enriched with Anthocyanin-Loaded Nanoliposomes: Sensory Evaluation and Physicochemical Stability During Cold Storage. International Journal of Molecular Sciences, 26(19), 9637. https://doi.org/10.3390/ijms26199637


